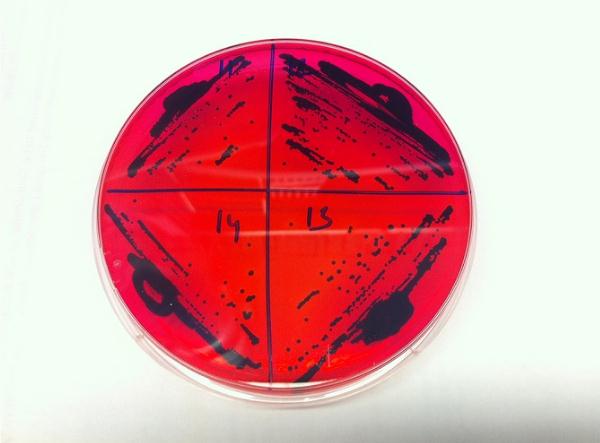

我們擅長(cháng)商業(yè)策略與用戶(hù)體驗的完美結合。
歡迎瀏覽我們的案例。
“超級細菌”是當前全球公共衛生領(lǐng)域面臨的一個(gè)大敵,因為即便目前最強的抗生素治療手段,都可能完敗于超級細菌的抗藥性。近日,外媒報道了一件令美國醫護人員感到頗為遺憾的事情 —— 他們首次在該國一名患者留存的樣本中,檢出了對“終極抗生素”有抗性的超級細菌基因 —— mcr-3.1 。
據悉,沙門(mén)氏菌是一種經(jīng)常引發(fā)食物中毒的細菌,通常它只會(huì )引發(fā)感染。但在抵抗力不佳的年輕人、或者免疫力受損的老年人身上,癥狀可能會(huì )嚴重得多。
通常情況下,醫護人員會(huì )提出通過(guò)抗生素來(lái)治療沙門(mén)氏菌感染。悲哀的是,與許多其它細菌一樣,目前沙門(mén)氏菌已經(jīng)對大多數抗生素藥物產(chǎn)生了抗藥性。
黏菌素被認為是抵抗超級細菌的終極手段,但現在我們直到,用不了多久,這座最后的堡壘都有可能被超級細菌給攻破。
外媒指出,一種被稱(chēng)作 mcr-3.1 的基因,可以讓沙門(mén)氏菌這樣的細菌,獲得對黏菌素的抵抗能力。
多年來(lái),這個(gè)危險的基因一直被公共衛生領(lǐng)域密切觀(guān)察著(zhù)。但現在,它已經(jīng)首次沖擊到了美國的海岸。
新研究通訊作者 Siddhartha Thakur 表示:“公共衛生官員對這種基因的了解,已經(jīng)有一段時(shí)間了”。
早在 2015 年的時(shí)候,他們就已經(jīng)知曉了 mcr-3.1 基因從染色體到質(zhì)粒的轉移,這一特性為該基因在生物體之間的轉移傳播鋪平了道路。
以大腸桿菌為例,因為它與沙門(mén)氏菌屬于同一家族,所以質(zhì)??梢栽趦烧咧g更加輕松地傳遞。一旦 mcr-3.1 不受控制,就會(huì )迅速擴散到至少 30 個(gè)國家和地區。
研究人員指出,新案例實(shí)在針對該基因的常規監測期間被發(fā)現的,該項目旨在對新菌株的耐藥性展開(kāi)持續密切的關(guān)注。
研究人員對 2014~2016 年間,來(lái)自美國東南部人群的 100 份臨床人體糞便樣本中的微生物進(jìn)行了基因組測序。
結果在其中一個(gè)樣本中,他們驚訝地發(fā)現了 mcr-3.1 基因 —— 該樣本來(lái)自去中國旅行后感染沙門(mén)氏菌的患者。
更糟糕的是,因為樣本來(lái)自于 2014 年,這意味著(zhù)該基因現在或許已經(jīng)在全美范圍內廣泛傳播,甚至已經(jīng)傳遞到了更加危險的大腸桿菌株系。
當然,超級細菌的出現,并不意味著(zhù)人類(lèi)將就此迎來(lái)末日。新的抗生素一直在積極研發(fā)中,抗菌燈和其它材料技術(shù)也在不斷發(fā)展。
通過(guò)將不同的新方法配對組合使用,研究人員有望找到應對 mcr-3.1 基因的新途徑,甚至一些較老的藥物、也有望在分子技術(shù)的加持下再次煥發(fā)活力。
有關(guān)這項研究的詳情,已經(jīng)發(fā)表在近日出版的《醫學(xué)微生物學(xué)》(Journal of Medical Microbiology)雜志上。
?。?a href="http://www.yyedu365.com/city/wuan/">武安網(wǎng)站建設)

小米應用商店發(fā)布消息稱(chēng) 持續開(kāi)展“APP 侵害用戶(hù)權益治理”系列行動(dòng) 11:37:04
騰訊云與CSIG成立政企業(yè)務(wù)線(xiàn) 加速數字技術(shù)在實(shí)體經(jīng)濟中的落地和應用 11:34:49
樂(lè )視回應還有400多人 期待新的朋友加入 11:29:25
亞馬遜表示 公司正在將其智能購物車(chē)擴展到馬薩諸塞州的一家全食店 10:18:04
三星在元宇宙平臺推出游戲 玩家可收集原材料制作三星產(chǎn)品 09:57:29
特斯拉加州San Mateo裁減229名員工 永久關(guān)閉該地區分公司 09:53:13